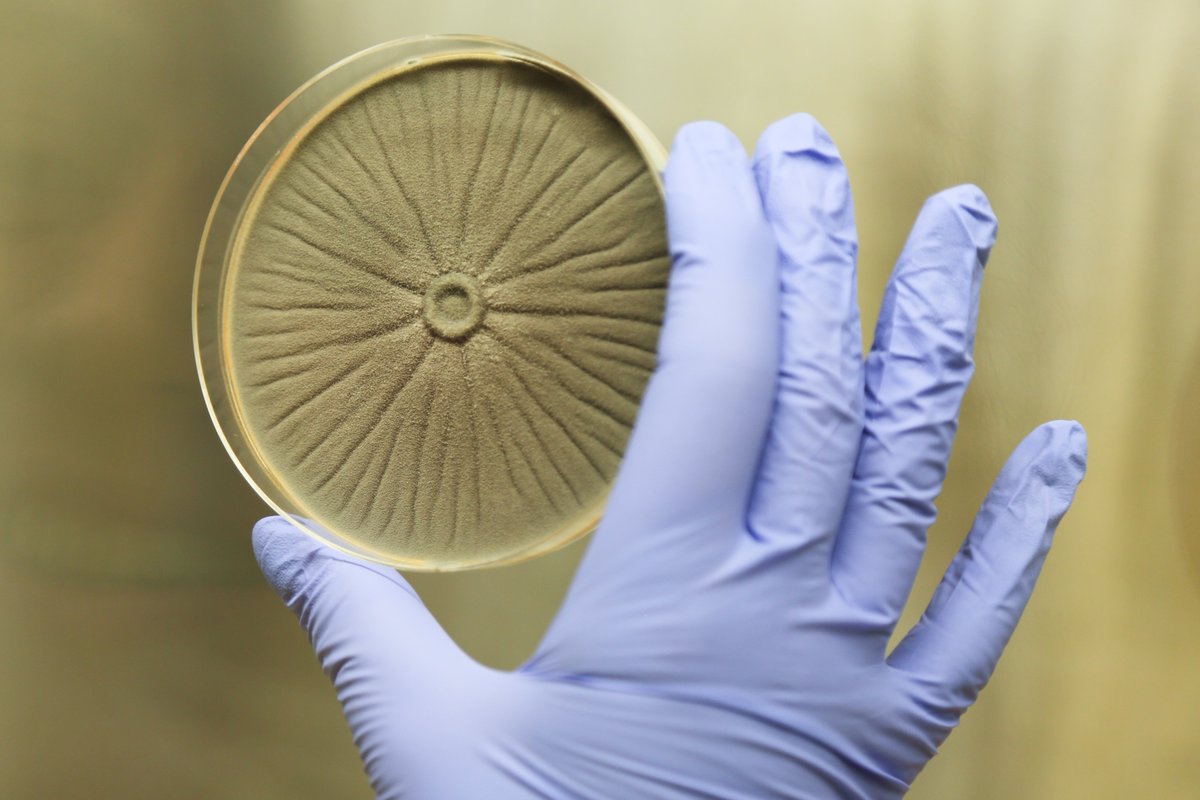
🌍 Dia Mundial da Aspergilose (1 fev): A doença causada pelo fungo Aspergillus afeta principalmente pessoas com imunidade comprometida, com mortalidade &gt;85%. Embora presente no ar, só gera risco p esses pacientes. A equipa i3D do ICVS luta contra essa ameaça! 🍄🫁 #WAD2025 #ICVS

ICVS
@icvs_uminho
ICVS: improving human health through outstanding life-science research, cutting-edge medical innovation and delivery of specialized services.
ID: 981441794276806656
http://www.icvs.uminho.pt/ 04-04-2018 08:02:12
1,1K Tweet
1,1K Followers
300 Following